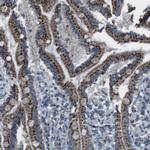
FAM3B Antibody in Immunohistochemistry (IHC)

Search
Invitrogen
FAM3B Polyclonal Antibody
{{$productOrderCtrl.translations['antibody.pdp.commerceCard.promotion.promotions']}}
{{$productOrderCtrl.translations['antibody.pdp.commerceCard.promotion.viewpromo']}}
{{$productOrderCtrl.translations['antibody.pdp.commerceCard.promotion.promocode']}}: {{promo.promoCode}} {{promo.promoTitle}} {{promo.promoDescription}}. {{$productOrderCtrl.translations['antibody.pdp.commerceCard.promotion.learnmore']}}

Please note: We are reviewing Western blot images included in the antibody testing data in our catalog, including those provided by third parties. Unless expressly labeled or annotated as “raw-unedited”, Western blot images included in the antibody testing data in our catalog may have been edited, optimized or otherwise adjusted for presentation.
产品信息
PA5-53397
种属反应
宿主/亚型
分类
类型
抗原
偶联物
形式
浓度
规格
纯化类型
保存液
内含物
保存条件
运输条件
RRID
产品详细信息
Immunogen sequence: TPCPSDTYAY RLLSGGGRSK YAKICFEDNL LMGEQLGNVA RGINIAIVNY VTGNVTATRC FDMYEGDNSG PMTKFIQSAA PKSLLFMVTY DDGSTRLNND AKNAIEALGS KEIRN
Highest antigen sequence identity to the following orthologs: Mouse - 77%, Rat - 75%.
靶标信息
FAM3B (family with sequence similarity 3, member B), also known as ORF9, C21orf11 or PANDER, is a 235 amino acid secreted protein that localizes to discrete vesicular and perinuclear structures. Expressed at high levels in pancreas and at lower levels in kidney, colon, testis, prostate and small intestine, FAM3B functions as an islet-specific cytokine that promotes apoptosis and may inhibit Insulin secretion from beta-cells, possibly playing a role in overall pancreatic activity. Human FAM3B shares 78% sequence identity with its mouse counterpart, suggesting a conserved role between species. Three isoforms of FAM3B, designated A, B and C, exist due to alternative splicing events.
仅用于科研。不用于诊断过程。未经明确授权不得转售。
篇参考文献 (0)
生物信息学
蛋白别名: 21-Feb; Cytokine-like protein 2-21; Pancreatic-derived factor; PANDER; Protein FAM3B
基因别名: C21orf11; C21orf76; FAM3B; PRED44; UNQ320/PRO365
Entrez Gene ID: (Human) 54097




